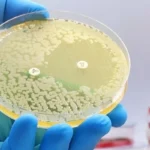
bacteria ready for microscope

What the PWTA Requires for Private Well Testing in New Jersey
- Published:
- Updated: October 10, 2025
Summary
The Private Well Testing Act (PWTA) in New Jersey establishes clear guidelines for ensuring safe drinking water. It requires regular testing for contaminants. Sellers must provide recent test reports to buyers, adhering to NJDEP standards.
This legislation aims to safeguard residents from harmful substances in private wells. By adhering to Well Testing in New Jersey protocols, both buyers and sellers gain essential information. This transparency is vital for real estate transactions.
- All private wells must be tested under the Private Well Testing Act (PWTA) in New Jersey.
- Property owners must offer recent water test results before a sale goes through.
- Common concerns include coliform bacteria, nitrates, and metals.
- Compliance with NJDEP guidelines safeguards household water quality.
- Early testing helps prevent costly issues and protects public health.
Understanding the Purpose of the Private Well Testing Act
The Private Well Testing Act is a critical measure aimed at safeguarding public health. It ensures that private well owners are aware of their water quality. Unlike public systems, which are overseen by agencies, private wells require special attention to prevent hidden contaminants.
This law mandates testing to enhance Drinking water safety and ensure PWTA compliance statewide. It alerts homeowners to possible dangers, such as bacteria and chemicals. If contamination is found, owners can take steps to mitigate risks and safeguard their families.
For those considering purchasing a property, access to these reports is invaluable. The act serves as a reliable safety net, facilitating informed real estate decisions. It promotes transparency and boosts confidence among all stakeholders involved.
Objective | Benefit |
Raise Awareness | Encourages early detection of contamination |
Promote Health | Guards families from waterborne illness |
Key Contaminants Tested Under PWTA
Officials evaluate numerous water quality parameters to protect private wells. Each test seeks to uncover pollutants that could harm those using well water. They look for signs of industrial runoff, aging pipes, or other risks from daily activities.
Common Bacteria and Microorganisms
Bacterial contamination can occur when waste enters a well through cracks or poor filtration. Tests for coliform bacteria and E. coli check if the water may contain fecal matter. Regular checks for these signs lower illness risks and prompt quicker corrective actions.
Heavy Metals and Chemical Compounds
Heavy metals testing includes lead, arsenic, and copper, which can seep into groundwater from corroded pipes or natural deposits. Health agencies also monitor chemical traces from volatile organic compounds in cleaning agents and fuel residues. Identifying these elements is critical for maintaining well integrity and safeguarding residents from harm.
Why Homeowners and Buyers Must Comply
Following clear guidelines for private well testing is essential to avoid unexpected issues. Real estate transactions heavily rely on accurate water quality data. This ensures both parties have peace of mind. Sellers who address water quality concerns early can prevent delays and disputes.
Legal Obligations
The NJ well testing law mandates sellers to conduct necessary water tests before a sale is finalized. Without compliance, the transaction can be halted. Buyers need documented results to confirm the property meets essential standards. Key steps include:
- Obtaining a certified analysis from an approved laboratory
- Sharing official test reports with prospective buyers
Health and Safety Considerations
Safe drinking water is critical for daily activities. Timely testing minimizes the risk of harmful exposure. It also provides valuable insights into possible contamination. Buyers can then plan for necessary repairs or negotiate terms confidently, ensuring the home’s condition.
Sampling Procedures and Best Practices
Water sampling in New Jersey requires meticulous attention to technique and timing. Accurate results depend on proper sampling. PWTA water sampling targets common contaminants, safeguarding families. It minimizes the risk of misjudging water quality.
Certified labs adhere to state guidelines for collection. To prevent contamination, many turn to professionals. They use sterile containers, document sample details, and deliver samples promptly. This method enhances confidence in results and reduces retesting needs. PWTA water sampling is a cornerstone for reliable outcomes, as recognized by the NJDEP.
For more detailed information, refer to this water testing guide. It delves into planning, handling, and storage, highlighting the necessity of trained technicians’ supervision. These methods are designed to meet stringent local health standards.
- Always use approved containers
- Label each sample immediately
- Send to the lab as quickly as possible
Key Tips for Reliable Outcomes
Phase | Action |
Preparation | Confirm lines are flushed before sampling |
Transport | Maintain stable temperature to preserve integrity |
How Results Are Reported to the State
Private well analyses are transmitted securely across New Jersey. State officials depend on precise water test documentation to monitor well quality in local areas. Labs submit official data, providing a reliable snapshot of contamination concerns. This method ensures NJDEP compliance and addresses hazards promptly.
State reporting allows all parties to access these readings. Homeowners gain clarity on water conditions, and regulators maintain valuable records. These records guide public health decisions.
Logging Results with State Databases
Data from each test is logged in official databases, creating a transparent archive of well performance. This log highlights recurring issues, enabling swift responses to contamination. All entries are accessible to authorized agencies for thorough evaluation and community updates.
Interpreting Water Quality Reports
Reports compare contaminant readings against acceptable thresholds. If values exceed set limits, treatment solutions or future inspections may be considered. Homeowners and buyers focus on clear guidelines for safe consumption levels. Regular checks reinforce public trust in local water sources.
Costs and Financial Responsibilities
Property owners often face unique demands when estimating testing fees for private wells. The person listing the home is expected to manage initial analysis expenses under most contracts. Clear communication between parties promotes transparency, preventing misunderstandings related to seller obligations.
Remediation costs may arise if contaminants exceed recommended thresholds. Some water issues can be solved with a small-scale filter, while others call for broader treatment solutions. Buyers might request shared payments to reduce surprise liabilities during final negotiations. Every step demands careful planning once test reports reveal any hidden problems.
Expense Category | Common Responsibility | Estimated Range |
Initial Testing Fees | Homeowner/Seller | $350 – $500 |
Filtration Setup | Buyer or Split | $200 – $900 |
Extensive Remediation Costs | Negotiable | $1,000 – $5,000+ |
Tips for Hiring a Certified Laboratory
Many homeowners look for expert help when getting a detailed private well analysis. It’s wise to first check a facility’s professional background. The New Jersey Department of Environmental Protection assures that a NJDEP-certified lab adheres to industry standards and maintains consistent results.
Some labs display their credentials online, making it simpler to verify their Laboratory accreditation. Public directories often list qualified testing facilities that follow strict sampling procedures. This ensures property owners can trust the data’s accuracy.
- Ask for proof of up-to-date credentials
- Confirm the lab’s chain-of-custody protocols
- Review any guidelines for specimen handling
“The EPA recommends thorough research when choosing a testing provider, ensuring credible findings for each well sample.”
A reliable partner offers quick results with clear communication. This is key to fulfilling legal requirements for private well analysis and ensuring water quality peace of mind.
Common Pitfalls and How to Avoid Them
Delays in closing can escalate when well contamination shows up after contracts are signed. Sellers risk stalled negotiations if they hold off on essential checks and repairs until the last minute. Spotting testing pitfalls early safeguards transactions and preserves trust between parties.
Inaccurate Sampling Techniques
Improper collection methods undermine reliable results. Samples taken too quickly or from dirty faucets can skew data. A few careful steps prevent confusion:
- Run cold water for a short time before filling containers
- Use only sterilized materials to avoid contamination
- Label and store each sample correctly
Delaying Necessary Repairs
Fractured casing or neglecting private well maintenance leaves room for contaminants. Prior fixes reduce the chances of future complications and make avoiding re-tests more likely. Support from local experts can help assess the system. This legal blog describes ways to address issues before they derail closings.
When to Retest Your Well Supply
Regular checks are essential to keep your home’s water quality high. Periodic well testing helps identify any changes that might occur over time. Some homeowners choose to test their wells more frequently if their property is on the market for over six months. This ensures the water remains safe and appealing to buyers.
Seasonal Changes and Flooding
Groundwater levels can rise, and heavy storms can flood areas, affecting water sources. These events can introduce new contaminants, leading to Seasonal contamination. By retesting, you can catch these issues early, minimizing risks. Simple steps, like checking the wellhead, help keep you informed about your water’s quality.
Major Home Renovations
Big construction projects can upset the soil and change water flow paths. Post-renovation water checks are vital to uncover hidden contaminants that might appear after the work is done. A detailed reevaluation ensures your water remains healthy and meets local standards, giving you peace of mind.
Well Testing in New Jersey: Meeting Local Requirements
Local testing guidelines in New Jersey vary significantly. Each county may introduce additional steps to the NJ well standards. This is due to concerns like saltwater intrusion in coastal areas or high iron levels in the north. Municipal rules often reflect these localized differences, ensuring water quality meets specific benchmarks.
Some homeowners find that local regulations require extra sampling for minerals or other region-specific issues. They are advised to follow these measures to safeguard public health and support a stable property market. By staying informed about evolving requirements, buyers and sellers can avoid unexpected delays.
Testing schedules can change over time. It’s essential to review official updates from municipal authorities before scheduling. This approach ensures each well’s unique traits are covered, maintains compliance, and preserves safe drinking water across the state.
Understanding the Role of Local Health Departments
Local health departments play a vital role in guiding property owners on well water management. They provide essential insights and support to ensure compliance with state guidelines. They offer fact sheets on contamination risks and tips for better sampling.
By doing so, they instill confidence in the safety of well water. Community members feel reassured knowing local officials are there to guide them.
Public Guidance and Educational Resources
Departments offer educational programs through workshops and brochures. These resources highlight best practices for filtering out impurities and addressing irregular results. They provide clear steps to fix contamination issues.
This knowledge empowers families to protect their drinking water for years to come.
Enforcement of PWTA Standards
Representatives review test outcomes and suggest necessary solutions. If issues continue, they take enforcement actions to ensure compliance. They work closely with laboratories and property owners to meet legal standards.
By enforcing clear rules, they maintain water quality for individuals across the state.
Navigating Real Estate Transactions with Private Wells
When a private well is involved in real estate, buyers often prioritize water quality. Laboratory tests confirm the water’s safety, ensuring a healthy source for all. Sellers promptly share these reports, building trust and keeping the deal moving forward.
Pre-Closing Inspection Protocol
Inspections examine the well’s structure and water flow. Closing checks involve reviewing field test results and system components. They also confirm recent maintenance. A certified lab’s report guides future actions, preventing unexpected issues.
Negotiating Repairs and Retesting
If contamination or mechanical problems arise, negotiating repairs is key. Sellers may address these issues and schedule a retest. Open communication between both sides builds confidence, smoothing the home transfer process.
Action | Purpose | Benefit |
Collect Official Lab Results | Document water quality | Establish baseline for negotiations |
Review System’s Maintenance History | Identify recurring issues | Prevent repeats and save costs |
Finalize Necessary Repairs | Address contamination or defects | Boost buyer confidence |
Retest After Repairs | Verify successful resolution | Satisfy lender and regulatory needs |
Ensuring Water Safety for Future Generations
Private wells are critical for local health and property standards. Regular testing catches small problems before they grow. Keeping detailed records tracks water quality changes over time.
Investing in sustainable water management safeguards loved ones and future residents. Long-term well care boosts property values and promotes a cleaner environment.

Regular maintenance keeps contaminants away, showing a commitment to safer living. Open communication among homeowners, real estate agents, and local officials builds confidence in private wells.
Ongoing maintenance fosters community trust. By consistently demonstrating responsible stewardship, individuals create a healthy legacy for future generations.
FAQ
What does the Private Well Testing Act (PWTA) require for New Jersey properties?
The PWTA mandates that any property in New Jersey with a private well must undergo water testing before a sale or transfer. Results must be disclosed to prospective buyers. This ensures transparency about the water’s safety and protects overall environmental health.
Why was the PWTA created, and how does it protect residents?
The PWTA was established to safeguard people who rely on private wells. It detects contaminants that local and federal agencies do not routinely monitor in public water systems. By enforcing regular tests, the Act upholds public health standards. It prevents residents from unknowingly consuming contaminated water.
Are PFAS and radon ever tested under the PWTA?
While the PWTA focuses on contaminants like coliform bacteria, nitrates, and metals, some regions or local agencies may recommend adding tests for emerging contaminants like PFAS or radon. Homeowners should check specific local requirements to ensure well water safety.
Which contaminants are commonly targeted during private well testing?
Tests typically screen for coliform bacteria, E. coli, heavy metals (like lead or arsenic), and volatile organic compounds (VOCs). Some areas may also include checks for pH or corrosion concerns. Balanced water chemistry helps preserve plumbing lines and reduce serious health risks.
Who must comply with the PWTA, and what happens if they do not?
Sellers of properties that include a private well are legally obligated to conduct and share water quality test results. Failure to comply can halt real estate transactions and lead to legal consequences. This highlights the importance of compliance guidelines set forth by the state.
How do sampling procedures ensure accurate test results?
Proper test procedures involve using clean containers, collecting samples in a sterile manner, and shipping them promptly to an NJDEP-certified lab. Many professionals recommend disinfection of sampling hardware or using qualified technicians. This minimizes the risk of contamination and guarantees reliable outcomes.
How are PWTA results reported to the state, and why is this essential?
Certified laboratories send findings to the New Jersey Department of Environmental Protection (NJDEP), which logs them in a state database. This official record ensures transparency, aids in tracking local water quality trends, and helps property owners make informed decisions about treatment solutions.
Who is responsible for covering testing and remediation costs?
In most real estate transactions, sellers pay for initial testing. If results exceed safe thresholds, remediation expenses can vary based on the contaminants involved. Buyers sometimes negotiate cost-sharing for advanced filtration systems or other corrective measures to finalize the deal smoothly.
Why is hiring a certified laboratory so important?
NJDEP-certified labs offer laboratory accreditation, follow strict testing protocols, and maintain rigorous quality control. Their validated methods reinforce trust in the final results. This helps both buyers and sellers meet regulatory requirements without delays in the transaction process.
What are common pitfalls to avoid when testing a private well?
Inaccurate sampling methods, overlooking seasonal test recommendations, and postponing well repairs can all produce unreliable results. By resolving issues in advance and adhering to proper procedures, property owners prevent costly re-testing. This maintains confidence in their water supply.
How do local requirements affect PWTA testing?
Certain municipalities or counties may mandate extra testing or stricter guidelines beyond state regulations. For example, regions prone to saltwater intrusion or elevated iron levels might require additional checks. This ensures that testing remains relevant to local water concerns.
What role do local health departments play in PWTA compliance?
Local health departments provide educational resources, sampling procedure guidance, and support to homeowners managing contaminated wells. They also help enforce PWTA standards. This ensures that property owners address any significant water quality issues promptly and effectively.
How does private well testing fit into real estate transactions?
During the due diligence phase, sellers typically arrange for PWTA-compliant tests. If problems arise, buyers may request remediation or further testing to confirm that contamination is resolved. Clear communication of test findings helps build trust and streamlines the closing process.
What steps can homeowners take to ensure ongoing water quality?
Regular testing, maintaining well infrastructure, and installing appropriate filtration or disinfection systems are key. Monitoring for emerging contaminants like PFAS or radon, keeping accurate records, and collaborating with certified professionals foster a culture of responsible ownership. This protects future generations.
Shedule Your Test Now!
Share this on social media: